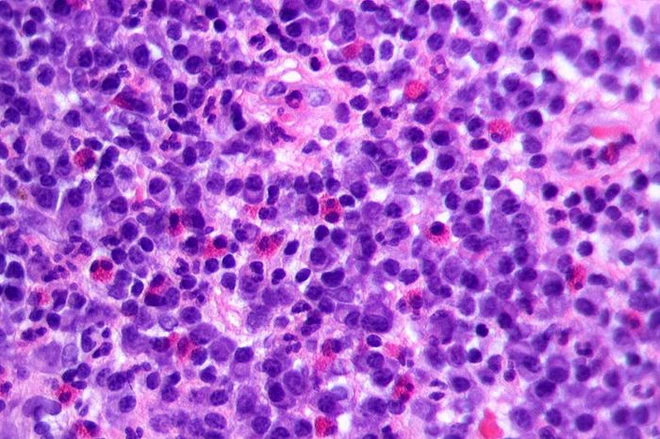
Giải ngố: Tập thể dục c&oacute; tạm thời l&agrave;m suy yếu hệ miễn dịch của bạn hay kh&ocirc;ng? - Ảnh 2.

Một phần ba các bề mặt trong phòng tập gym có khả năng trở thành nơi trung gian lây nhiễm mầm bệnh.
Có người cho rằng câu hỏi đó thật thật ngớ ngẩn. Chúng ta được dạy từ nhỏ rằng thể dục tốt cho sức khỏe. Thể dục tăng cường hệ miễn dịch và sức đề kháng. Năng vận động sẽ giúp bạn chống lại mọi mầm bệnh, bao gồm cả virus SARS-CoV-2 mới đang gây ra dịch Covid-19.
Thế nhưng, bạn cứ thử nhớ lại cái ngày đầu tiên bạn đến phòng gym hoặc chạy được 5 km mà xem, có thể giống với nhiều người, bạn đã phải về nhà với một cổ họng khô rát và hai bên mũi sụt sịt. Sau đó, có vẻ như bạn đã bị ốm vì tập thể dục.
Một người trưởng thành từ những năm 1980, nghĩa là bây giờ họ đã trên dưới 40 tuổi, có thể nói với bạn rằng: Đừng tập luyện vội, dịch Covid-19 không phải khoảng thời gian tốt vì những người mới bắt đầu tập thể dục sẽ bị suy yếu hệ miễn dịch trong một khoảng thời gian ngắn.
Bạn nhớ lại cái cảm giác khô rát ở họng và tự hỏi điều đó có thật hay không? Tập thể dục có thực sự tạm thời cản trở khả năng miễn dịch của cơ thể?

Giả thuyết “cửa sổ mở”: Khi các tế bào miễn dịch mất tích khỏi dòng máu
John Campbell, giáo sư khoa học sức khỏe tại Đại học Bath ở Anh, đồng thời là tác giả của một nghiên cứu đánh giá tổng hợp có ảnh hưởng về tập thể dục và hệ miễn dịch năm 2018 cho biết:
Vào những năm 1980, thực sự đã có những nghiên cứu báo cáo một hiện tượng lạ, rằng các vận động viên chạy marathon rất hay mắc các triệu chứng của bệnh truyền nhiễm trong vòng vài ngày cho đến vài tuần sau cuộc đua của họ.
Bắt đầu từ nghiên cứu này, một giả thuyết được xây dựng cho rằng khi cơ thể bị quá tải do tập luyện thể dục, thể thao, hệ miễn dịch của bạn cũng quá tải theo khiến mầm bệnh truyền nhiễm dễ xâm nhập. Giả thuyết này có thể đặc biệt đúng trong trường hợp bạn là một người mới bắt đầu tập luyện và thường tập quá sức ngay trong buổi đầu tiên.
Một số nghiên cứu gợi ý rằng một bài tập luyện nặng nhọc duy nhất cũng đã tạm thời làm giảm các phản ứng miễn dịch của chúng ta ngay sau đó, khiến chúng ta có nguy cơ cao bị nhiễm bệnh truyền nhiễm cơ hội sau buổi tập.
Khả năng này được gọi là lý thuyết cửa sổ mở, và nó đã được củng cố bằng một số thí nghiệm trên cả động vật và con người cho thấy sau mỗi buổi tập thể dục, các tế bào miễn dịch sẽ tràn vào máu của chúng ta, nhưng sau đó chúng đột ngột biến mất.
Một số nhà nghiên cứu đã xét nghiệm máu của các tình nguyện viên ngay trước, trong khi và ngay sau buổi tập luyện và phát hiện các tế bào miễn dịch mất tích. Họ cho rằng chúng có thể đã bị giết chết vì cường độ bài tập quá nặng.
Sự biến mất của một lượng lớn tế bào miễn dịch dường như để hở cánh cửa sổ cho các mầm bệnh cơ hội có thể xâm nhập và lây nhiễm cơ thể, trước khi các tế bào miễn dịch mới phục hồi.

Giải ảo: Tập thể dục về cơ bản không làm suy yếu mà còn tăng cường hệ miễn dịch
Sự thật là giả thuyết cửa sổ mở chỉ tồn tại trong một giai đoạn, ở đó một số nhà nghiên cứu đã mắc sai lầm. Các nghiên cứu xem xét kỹ lưỡng hơn đã xác nhận, không phải vì trong máu bạn có ít tế bào miễn dịch hơn thì cơ thể sẽ dễ bị tổn thương trước mầm bệnh hơn.
Trong một thí nghiệm hết sức tinh vi trên chuột, các nhà đã đánh dấu một số tế bào miễn dịch của chúng bằng thuốc nhuộm lân quang, rồi sau đó ép lũ chuột chạy đến khi kiệt sức mới thôi. Họ theo dõi các tế bào phát quang trong máu chuột và thấy số lượng của chúng tăng vọt rồi sau đó giảm mạnh, đúng như mô hình mà các nghiên cứu trước đã tìm thấy.
Nhưng phát hiện sau đó mới thực sự thú vị. Sau khi tập thể dục đến kiệt sức, chỉ có một số ít tế bào miễn dịch của những con chuột bị chết. Đa số các tế bào khác biến mất trong dòng máu, bởi vì chúng đã đi đến phổi, ruột và các cơ quan nội tạng dễ bị tổn thương nhất của chuột.
Chúng tới đó để bảo vệ cơ thể chúng khỏi những mầm bệnh cơ hội. Sau vài tiếng đồng hồ làm nhiệm vụ “canh gác” ở các cơ quan này, tế bào miễn dịch đã trở lại dòng máu. Chúng không hề bị suy giảm.
Tương tự, trong một nghiên cứu được công bố năm 2019, các nhà khoa học đã tiêm những con vi trùng gây bệnh vào hai nhóm chuột. Một là những con chuột ít vận động, và hai là những con chuột vừa chạy mệt.
Kết quả là những con chuột chạy đến mệt mỏi vẫn chống lại vi khuẩn tốt hơn, vì các tế bào miễn dịch trong máu của chúng tập trung và bám vào mầm bệnh nhiều hơn. Trong máu những con chuột lười vận động, tế bào miễn dịch có xu hướng phân tán hơn và không tụ lại để chống lại vi khuẩn hiệu quả.
Nhưng tại sao bạn lại sụt sịt sau buổi tập đầu tiên?
Trở lại với nghiên cứu trên các vận động viên marathon, các nhà khoa học thực hiện nó cũng đã mắc sai lầm trong thiết kế thí nghiệm. Họ chỉ dựa trên những lời báo cáo tự chẩn đoán của vận động viên về triệu chứng hô hấp hoặc ngạt mũi của mình.
Một số nghiên cứu sau đó kiểm tra lại kết quả của nghiên cứu này, được thực hiện dựa trên việc theo dõi khách quan các vận động viên marathon sau các cuộc đua cho thấy một thực tế: rất ít người trong số họ bị nhiễm trùng đường hô hấp. Họ chỉ bị các triệu chứng như mắc bệnh vì đã bị kích thích đường thở trong cuộc đua, hoặc do các tình trạng không nhiễm trùng khác.
Điều này cũng có thể đúng với những người mới tập thể dục ngày đầu. Khi đó, mọi người thường tập quá sức và không bù nước đầy đủ. Đó có thể là nguyên nhân khiến cổ họng và đường hô hấp của bạn bị khô, từ đó bị kích thích nhiều hơn và gây ra các triệu chứng như viêm họng và chảy nước mũi.
Tuy nhiên, các nghiên cứu tiếp theo sau đó đã xác định rằng vận động viên marathon và các vận động viên cạnh tranh sức bền khác có ít ngày ốm trong năm hơn người bình thường, ngụ ý rằng hệ thống miễn dịch của họ không bị quá tải do tập thể dục mà ngược lại còn được củng cố.
Kể từ đó, rất nhiều nghiên cứu ở cả người và động vật đã ủng hộ giả thuyết mới này. Chẳng hạn, một loạt các thí nghiệm năm 2005 với chuột cho thấy: nếu những con chuột chạy bộ nhẹ nhàng trong khoảng 30 phút mỗi ngày trong vài tuần, chúng có nhiều khả năng sống sót dưới sự phơi nhiễm mầm bệnh cúm gây tử vong hơn so với chuột không được huấn luyện.
Vì vậy, tập luyện thể dục sẽ thực sự giúp bạn khỏe mạnh hơn, chứ không tạo cơ hội cho mầm bệnh xâm nhập và khiến bạn bị ốm.

Đừng tập quá sức và cảnh giác với các bề mặt trong phòng gym
Các nghiên cứu ủng hộ lý thuyết “cửa sổ mở” của hệ miễn dịch và tập thể dục đã đều bị bác bỏ. Thay vào đó, khoa học mới nhất chỉ ra rằng không hề có bằng chứng đáng tin cậy nào cho thấy việc tập thể dục trực tiếp làm tăng cơ hội nhiễm bất kỳ loại virus nào, giáo sư James nói.
Vì vậy, sẽ là an toàn khi mọi người tập thể dục và bắt đầu tập thể dục trong dịch Covid-19. Tập thể dục có thể giúp bạn giảm nguy cơ mắc bệnh, ông cho biết thêm.
Mặc dù vậy, có hai điều bạn cần đặc biệt lưu ý. Đó là hai tình huống đúng là có thể khiến bạn bị ốm khi đi tập thể dục.
Thứ nhất, bạn không nên tập luyện quá sức. Một nghiên cứu năm 2005 trên chuột và virus cúm cho thấy những con chuột chạy đến kiệt sức dễ bị mắc bệnh với các triệu chứng kéo dài hơn những con chuột chỉ chạy ở mức độ vừa phải, mặc dù sự khác biệt này rất nhỏ.
Công bằng mà nói, khi bạn tập thể dục với cường độ quá nặng trong thời gian quá dài, đặc biệt là ở những người mới tập, có thể điều đó sẽ gây ra những tác động tiêu cực nhất thời tới hệ thống miễn dịch, Jeffrey Woods, một giáo sư về sức khỏe cộng đồng tại Đại học Illinois ở Urbana-Champaign cho biết.

Tạ tay, thanh xà kéo, tạ tấm và tay cầm ở máy chạy bộ là những bề mặt dễ lan truyền mầm bệnh nhất trong phòng tập thể dục.
Điều thứ hai cần lưu ý khi tập thể dục trong mùa dịch, đó là bản thân phòng tập cũng có thể trở thành một địa điểm cao có nguy cơ lây lan bệnh truyền nhiễm. Một nghiên cứu năm 2019 chỉ ra tạ tay, thanh xà kéo, tạ tấm và tay cầm ở máy chạy bộ là những bề mặt dễ lan truyền mầm bệnh nhất trong phòng tập thể dục.
Do đó, bạn cần cân nhắc khi có ý định tới phòng gym. Nếu thấy không khỏe, bạn nên tránh đi tập thể dục. Nếu ở phòng tập có một người có triệu chứng ho, hắt hơi, tốt nhất bạn hãy giữ khoảng cách với họ.
Đừng chạm tay lên mặt ở phòng tập và phải rửa tay trước và ngay sau khi bạn kết thúc buổi tập của mình. Bạn cũng có thể yêu cầu phòng tập thường xuyên lau chất khử khuẩn lên các bề mặt tiếp xúc cao để giữ an toàn cho hội viên.
Nghiên cứu năm 2019 đã chỉ ra tới một phần ba các bề mặt trong phòng tập gym có khả năng trở thành nơi trung gian lây nhiễm mầm bệnh.
*Tham khảo thêm các biện pháp phòng ngừa dịch bệnh Covid-19 tại đây.
Tham khảo Nytimes
NỔI BẬT TRANG CHỦ
-

Vụ lộ mã nguồn Claude Code: Cursor, GitHub Copilot được hưởng lợi, nhưng thứ quan trọng nhất vẫn khó lòng mà copy được!
Khi source code Claude Code bị lộ ngày 31/3, tờ Axios tổng kết ngắn gọn: "Vụ lộ này sẽ không nhấn chìm Anthropic, nhưng nó cho mọi đối thủ một khóa học miễn phí về cách xây dựng công cụ AI coding hạng nặng." Nhưng "học phí miễn phí" không có nghĩa là ai cũng sẽ học được điều quan trọng nhất.
-

Mô hình toán học của MIT cho thấy: Sự "ba phải" của AI như ChatGPT đang cuốn người dùng vào vòng xoáy hoang tưởng